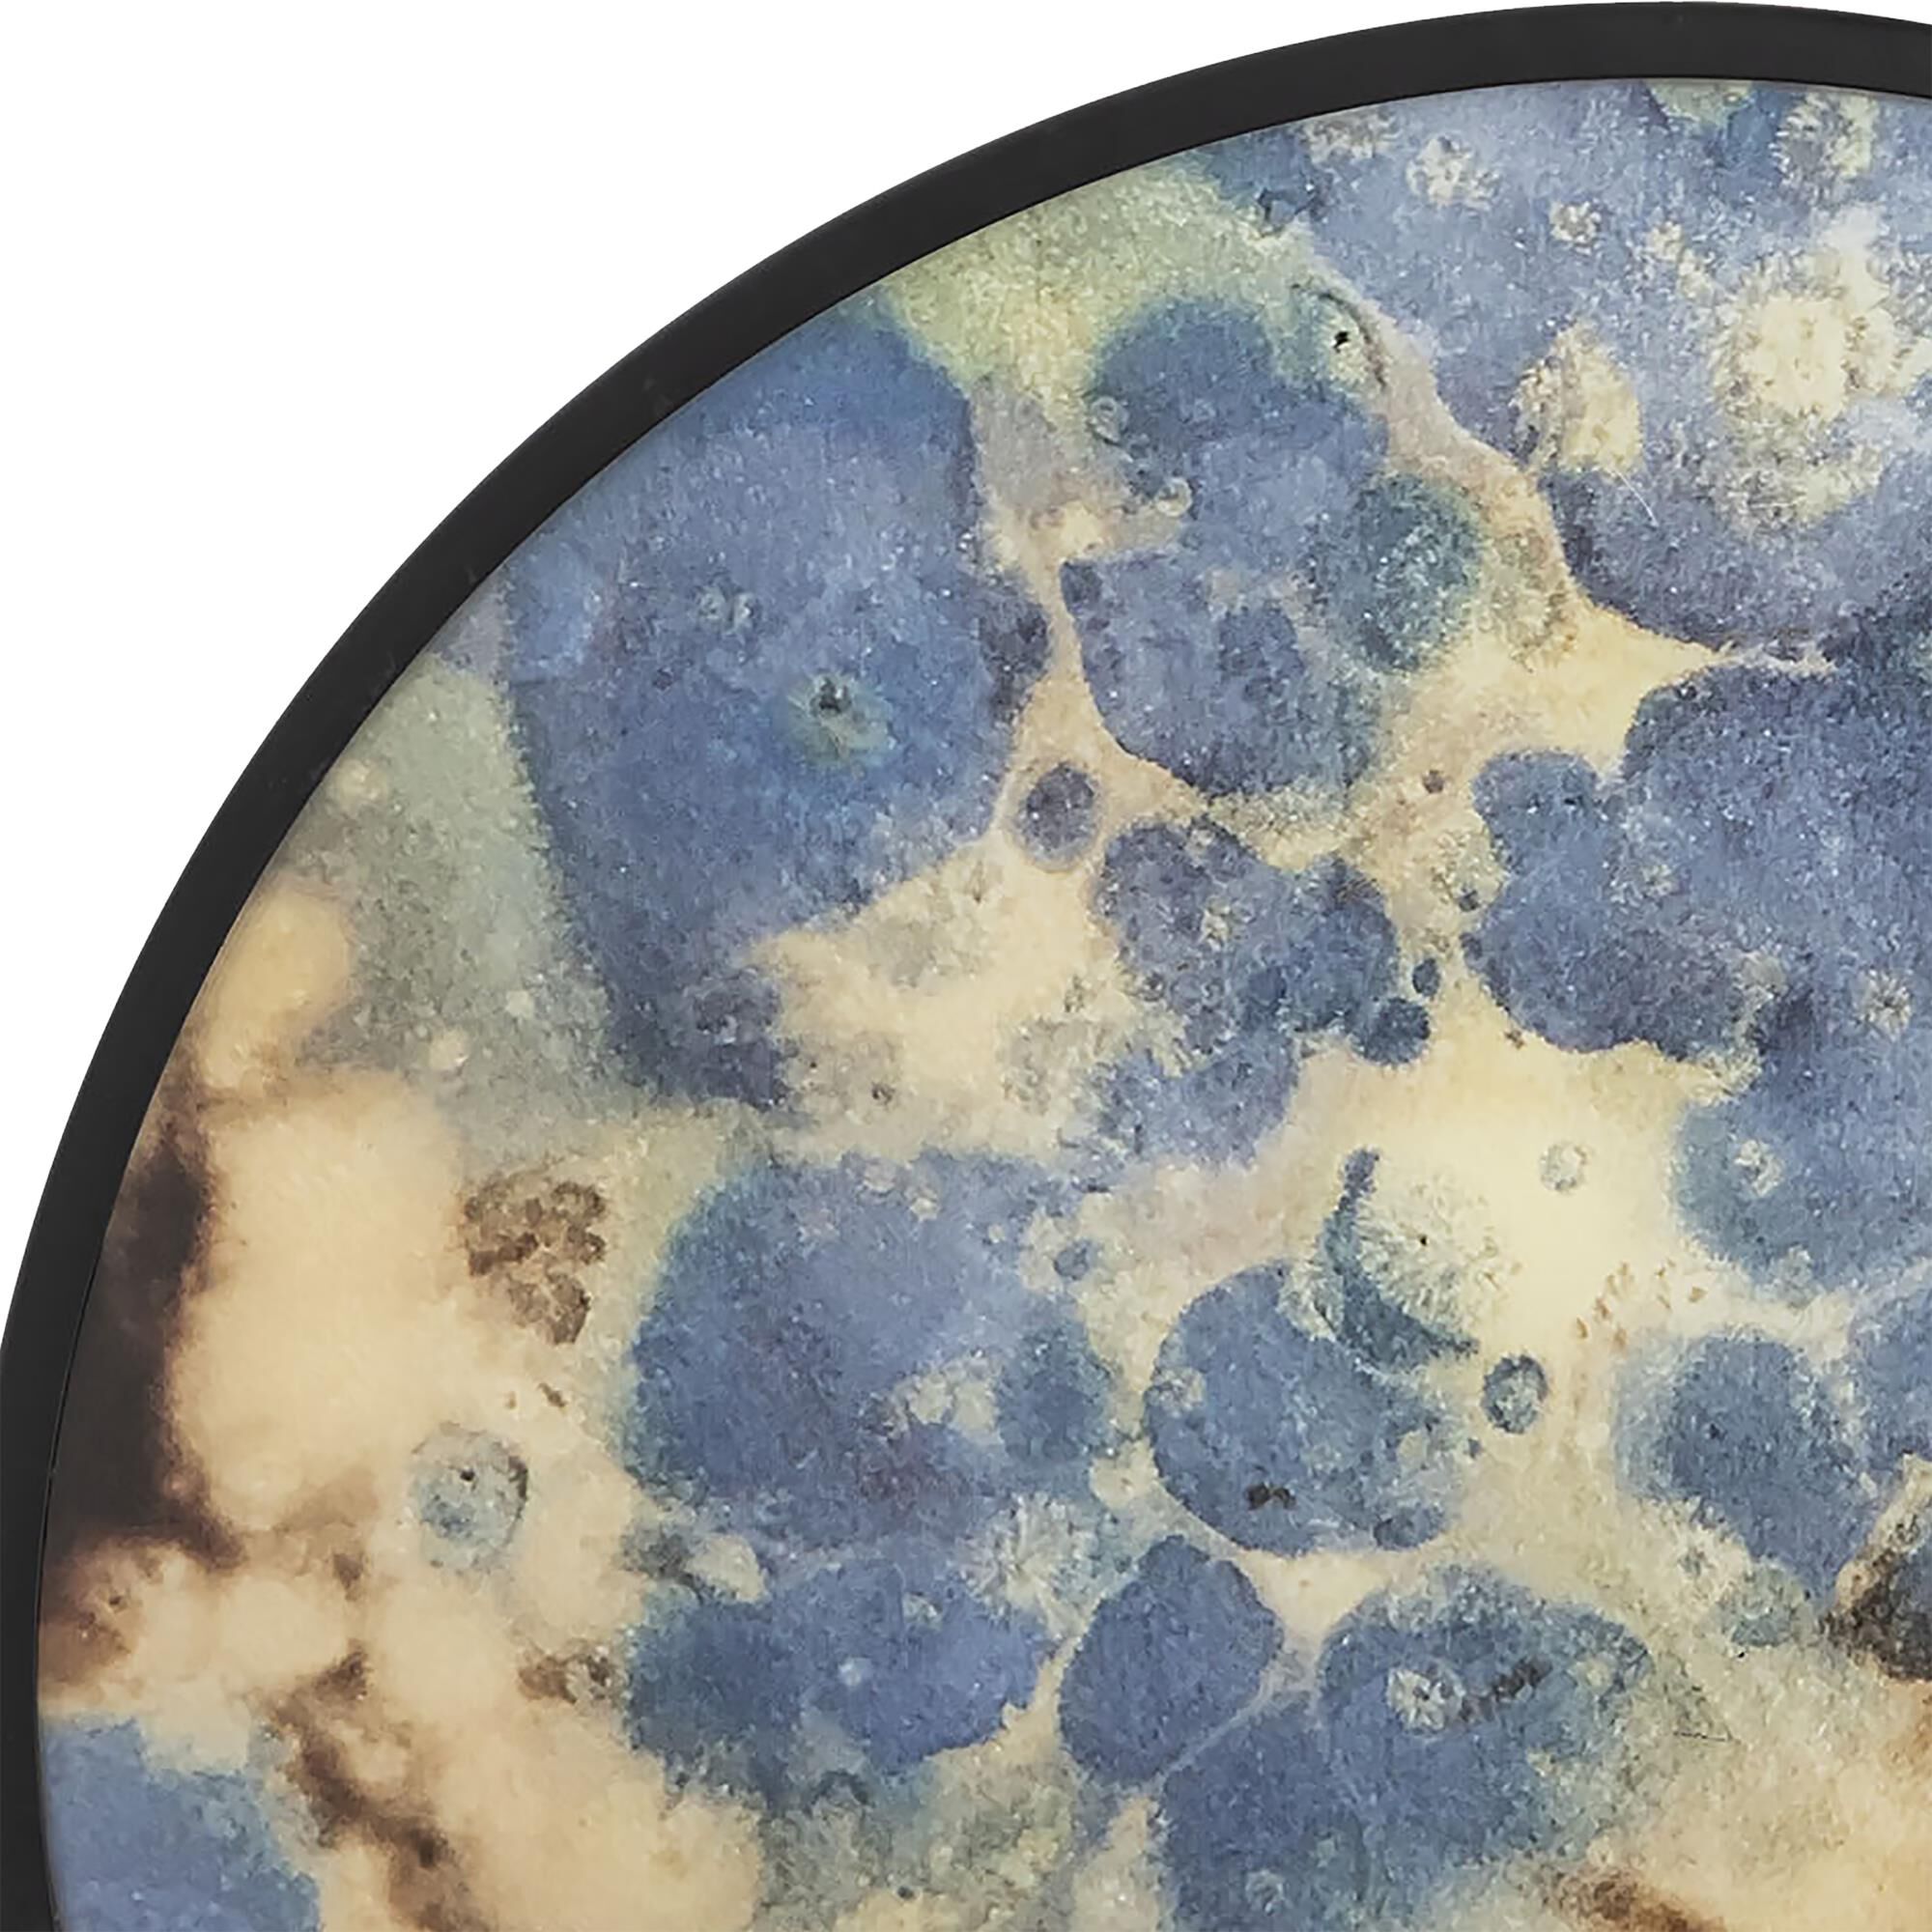
Hargrove Tray by ELK Home

Free Ground Shipping on Orders Over $49 Details & Exclusions Excludes Curb Side Delivery (LTL). Lower 48 United States Only. • NEW! Shop The Winter Lookbook
Hargrove Tray by ELK Home
Hargrove Tray by ELK Home

Questions about this product?
Our certified experts are here to provide personalized service 7 days a week.
- 110% price protection guarantee
- expert answers to your questions
- info about our trade professionals program
- free specialized projects consulting
contact our experts today
- Product Info
- Questions
- About the brand
- More from this collection
- Return policy
Product Info
Overview
The Hargrove wall art/tray is a round metal piece featuring an abstract geometric painted interior. Watery splashes of gold, blue and brown painted into the tray's interior make a dynamic artistic statement.
Product Dimensions
Height: 35.0 Inches
Width: 35.0 Inches
Depth: 6.0 Inches
Product Weight: 18.52 Pounds
Questions
Ask a question
About the brand
More from this collection
Return policy
-
Return it for 90 days! Capitol Lighting prioritizes the customer experience above all else. We want to make sure the products you purchase from us meet all of your expectations. All uninstalled non-closeout and non-custom products may be returned within 90 days of receipt. Simply call 1.800.544.4846 or chat with us to start your return and we'll issue your return shipping labels or help arrange pickup on your behalf (for oversized products).
General Return Policy
-
Worried about damages or defective items? Capitol's got you covered with our Damaged and Defective Protection!
Reviews